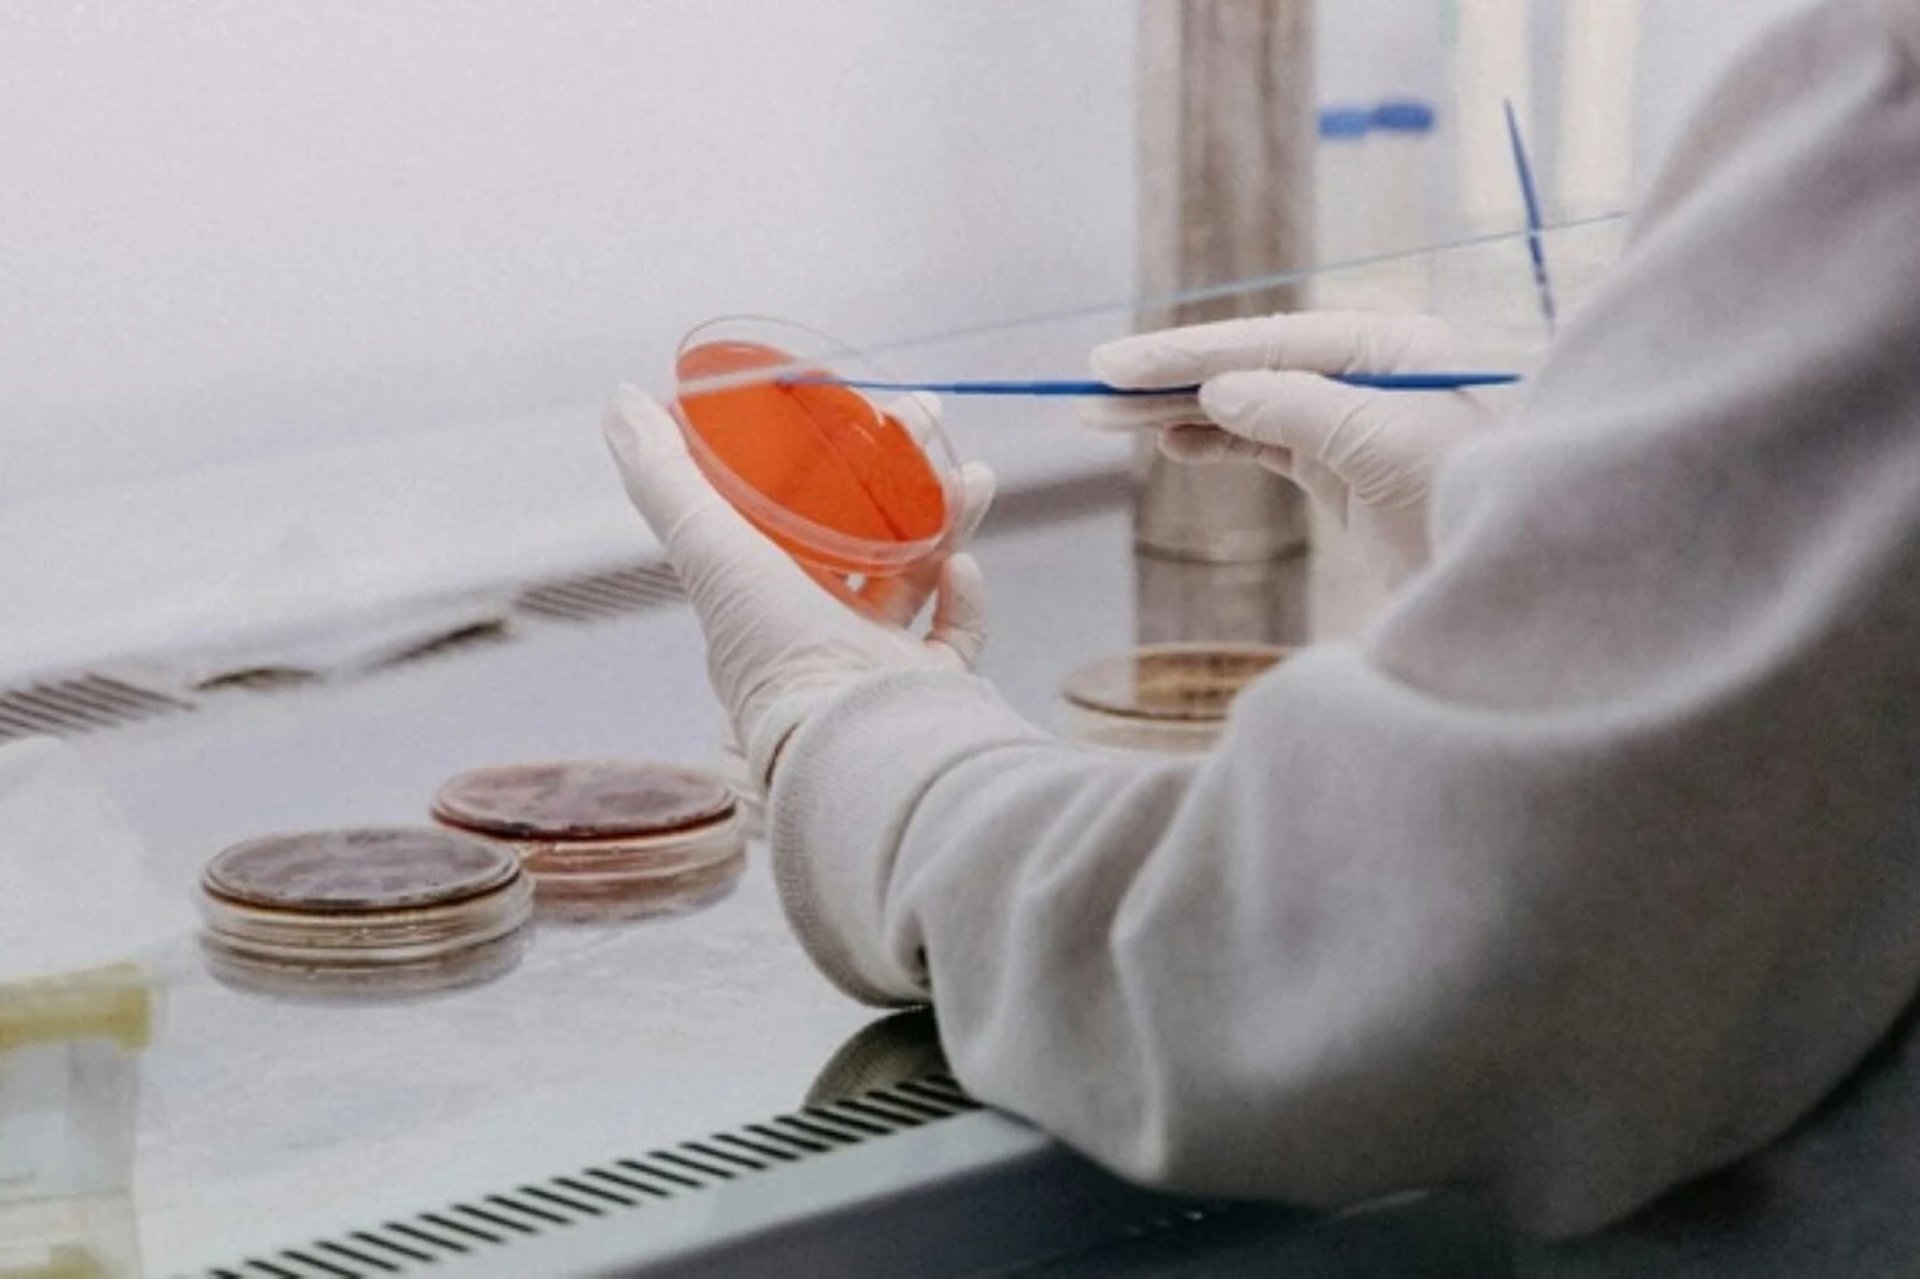

На Львівщині поліція розслідує отруєння дітей через спалах кишкової інфекції
У всіх спостерігали нудоту, блювоту, біль у животі та діарею
Сьогодні, 29 березня, під час моніторингу соціальних мереж правоохоронці виявили публікацію, в якій йшлось про те, що у період від 27 до 29 березня в один із медичних закладів міста Сокаль з симптомами гострої кишкової інфекції було госпіталізовано кількох дітей - вихованців одного з дитячих садочків міста віком 4 — 5 років. Про це інформує поліція Львівщини.
Станом на 29 березня на 18.00 у медзакладі перебуває десятеро дітей. Усі вони під наглядом лікарів, загрози їх життям немає.
Слідчі територіального підрозділу поліції, за процесуального керівництва Шептицької окружної прокуратури, розпочали кримінальне провадження за ч.1 ст.325 (Порушення санітарних правил і норм щодо запобігання інфекційним захворюванням та масовим отруєнням) Кримінального кодексу України. Санкція статті передбачає покарання - штраф від тисячі до трьох тисяч неоподатковуваних мінімумів доходів громадян або арешт на строк до шести місяців, або обмеження волі на строк до трьох років, або позбавлення волі на той самий строк.
Проводиться досудове розслідування, правоохоронці встановлюють обставини події, призначені експертизи.
varta1.com.ua: Новини
Читайте також

В Україні запровадять обовʼязковий техогляд для всіх авто
Євросоюз нам поставив цей критерій змін до кінця 2027 року

Після ударів РФ ЄС підтвердив посилення підтримки України
ЄС надає підтримку по всій Україні, щоб вона змогла витримати і пережити цю війну терору

Зеленський оцінив роботу ППО під час нічної російської атаки
Зеленський додав, що проблему нестачі перехоплювачів для балістики він обговорив на зустрічі з нідерландським прем'єром
Найкоментованіше
- Києво-Печерську лавру тимчасово закрили для відвідувачів
- Українців хочуть карати великими штрафами та тривалим ув’язненням за образу військових
- У центрі Львова невідомі нищать обладнання і сантехніку інклюзивної громадської вбиральні (ВІДЕО)
- У Львові з 1 липня пропонують змінити правила для електросамокатів
- На Львівщині фермер переорав макове поле на якому масово фотографувалися люди
Найчитаніше
- У Львівському ТЦК відреагували на заяву адміністратора "Трухи" Максима Лавриненка
- У Львові люди масово скаржаться на клініку для наркозалежних
- Підтверджено загибель Героя зі Львівщини, який з 2022 року вважався безвісти зниклим
- Стали відомі подробиці смертельної автопригоди в якій електромобіль впав у річку на Львівщині
- У Львові перевірять роботу клініки, на яку скаржаться місцеві жителі


Коментарі
Тут все стабільно. Львів - столиця отруєнь.